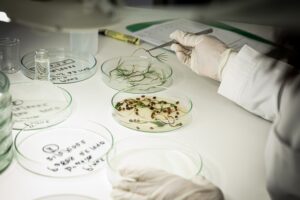

Πηγή Εικόνας: Motor Oil
Πηγή Εικόνας: Motor OilΜε όραμα την προστασία του φυσικού περιβάλλοντος και της βιοποικιλότητας αλλά και τη βιώσιμη επιχειρηματική λειτουργία και ανάπτυξη, η Motor Oil τον Οκτώβριο του 2021, ξεκίνησε την ουσιαστική στήριξη του Κέντρου Επεξεργασίας, Ελέγχου και Πιστοποίησης του Δασικού Πολλαπλασιαστικού Υλικού της Γενικής Διεύθυνσης Δασών και Δασικού Περιβάλλοντος του ΥΠΕΝ, στην Αμυγδαλέζα Αττικής.
Σ’ αυτήν την κατεύθυνση, υπογράφηκε στις 19 Μάϊου Μνημόνιο Συνεργασίας για την ενίσχυση της υποστήριξης του Δασικού Φυτωρίου της Διεύθυνσης Αναδασώσεων Αττικής στην Αμυγδαλέζα, μεταξύ του ΥΠ.ΕΝ και της Motor Oil, από τον κο Ευάγγελο Γκουντούφα, Προϊστάμενο της Γενικής Διεύθυνσης Δασών και Δασικού Περιβάλλοντος και τον κο Ιωάννη Κοσμαδάκη, Αναπληρωτή Διευθύνοντα Σύμβουλο της εταιρείας. Βασικοί στόχοι της συνεργασίας είναι η αύξηση της παραγωγής φυτευτικού υλικού για την κάλυψη των αναγκών του Εθνικού Σχεδίου Αναδασώσεων που θα υλοποιηθεί τα επόμενα χρόνια και, παράλληλα με τη δημιουργία επάρκειας σε φυτά για την εκτέλεση λοιπών έργων αποκατάστασης υποβαθμισμένων δασικών οικοσυστημάτων, η καλλιέργεια και η διατήρηση δέντρων της ελληνικής βιοποικιλότητας αλλά και η περαιτέρω συμβολή του φυτωρίου στη σπορά σπάνιων μεσογειακών ειδών.
Ταυτόχρονα, η συνεργασία περιλαμβάνει τον εκσυγχρονισμό του φυτωρίου με απαραίτητο υλικοτεχνικό εξοπλισμό αλλά και την εξασφάλιση των κατάλληλων συνεργατών που θα απασχοληθούν για την επίτευξη του σκοπού του έργου.
Πηγή Εικόνας: motor oil
Πηγή Εικόνας: motor oil
Ο Προϊστάμενος της Γενικής Διεύθυνσης Δασών και Δασικού Περιβάλλοντος, κος Ευάγγελος Γκουντούφας, δήλωσε σχετικά: «Είναι μεγάλη η χαρά μας να δεχόμαστε τέτοιες συνεργασίες και πρωτοβουλίες όπως αυτή του ομίλου Motor Oil. Η επέκταση της συνεργασίας μας, που ξεκίνησε τον Οκτώβριο του 2021, επιβεβαιώνει πως ενδιαφερόμαστε αμφότεροι να εξελίξουμε αποτελεσματικά το Εθνικό Σχέδιο Αναδασώσεων και μέσω αυτού την αποκατάσταση των δασών μας, ξεκινώντας από τη βάση της πυραμίδας που είναι οι σπόροι και τα φυτάρια. Η στήριξη της Motor Oil, για μια ακόμη φορά, μας δίνει το κίνητρο να θέτουμε ακόμη μεγαλύτερους στόχους διατηρώντας την προστασία της φυσικής κληρονομιάς της χώρας μας ως απόλυτη προτεραιότητα της πολιτείας μας» .
Ο κος Ιωάννης Κοσμαδάκης, Αναπληρωτής Διευθύνοντας Σύμβουλος της Motor Oil επεσήμανε: «Πριν 2 χρόνια θέσαμε τις βάσεις για μια δική μας ουσιαστική συμβολή στο μέλλον του δασικού πλούτου της χώρας μας. Σήμερα, προχωράμε ένα βήμα πιο πέρα την υποστήριξή μας στο φυτώριο της Αμυγδαλέζας στοχεύοντας στη διατήρηση της ελληνικής βιοποικιλότητας. Σκοπός μας είναι η εν λόγω συνεργασία με το Υπουργείο Περιβάλλοντος και Ενέργειας να ισχυροποιηθεί και να αποτελέσει υπόδειγμα βέλτιστων πρακτικών περιβαλλοντικής αναβάθμισης και βιωσιμότητας.» .
Για τη Motor Οil αποτελεί δέσμευση να συμβάλει με κάθε τρόπο σε τόσο άμεσους όσο και μακροπρόθεσμους στόχους βιώσιμης ανάπτυξης. Ο Όμιλος σε συνεργασία με αρμόδιους φορείς και τις τοπικές κοινωνίες όπου δραστηριοποιείται, εφαρμόζει και υλοποιεί με συνέχεια και συνέπεια μία συνολική στρατηγική, η οποία εστιάζει στη διατήρηση και προστασία του φυσικού περιβάλλοντος αλλά και τις επιπτώσεις της κλιματικής αλλαγής. Σε αυτό το πλαίσιο εντάσσεται και η συμφωνία του Ομίλου με το ΥΠ.ΕΝ, η οποία μάλιστα έρχεται σε συνέχεια της υιοθέτησης του δασικού εκκοκκιστηρίου της Αμυγδαλέζας από τον Όμιλο, με στόχο τη στήριξη του κέντρου επεξεργασίας, ελέγχου και πιστοποίησης του δασικού πολλαπλασιαστικού στην Αμυγδαλέζα.















